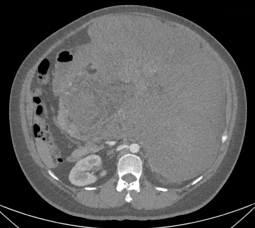
from clipboard

职位推荐
- 珍格医疗-临床销售 15001-20000
- 地奥制药-医药代表 6001-8000
- 普利德医疗-医疗设备销售经理 面议
- 大唐-兼职招商经理 面议
- 景德中药-直营经理 6001-8000
- 安邦医药-省区招商经理 8001-10000
- 恒瑞医药-医药信息沟通专员 6001-8000
- 黄河中药-学术讲师 8001-10000
发布日期:2024-08-20 浏览次数:167
近日,我院血管外科赵纪春教授团队联合多学科团队成功为一名女患者实施巨大腹膜后肿瘤根治性切除术。肿瘤累及血管与多脏器,切除后称重达32斤。目前,患者已康复出院,腹部压迫症状已完全改善,患者已恢复正常进食。
患者小吴今年34岁,近2年来体重持续增加,这让其误以为只是嘴馋而已,随着腹部压迫感日益加剧,活动后心累的情况逐渐增多,她意识到问题的严重性,遂前往当地医院就诊。医院检查发现,小吴腹膜后及腹腔内有一巨大肿块,且侵犯多个腹腔脏器、累及腹腔内多根重要血管。面对巨大肿块,多家医院均难以提供确切有效的手术方案。2024年7月1日,小吴来到我院血管外科赵纪春教授的诊室就诊,此时她的腹部已肿胀如临盆的孕妇,生命安全受到严重危及。
经进一步检查,患者小吴腹膜后及腹腔内藏着一个巨大的肿块,主体主要位于左中上腹,向下达盆腔入口,较大层面横切面约31.4×28.4cm,肿块推挤腹腔脏器,胰腺、胃、十二指肠向右前移位,脾脏向上移位,左肾向后移位,相应结构受压稍变形,胰腺部分显示不清,部分病灶包绕左肾及左肾上腺;病灶推挤肠管,部分与肠管分界不清。
考虑肿瘤体积巨大,赵纪春教授团队将小吴紧急收治入院,第一时间启动术前全面评估与讨论。为了尽量减少手术过程的损伤以提高患者的生活质量,赵纪春教授团队联合麻醉科、胃肠外科、胰腺外科、肝脏外科、输血科、重症医学科等多个科室进行MDT讨论,为患者制定了涉及多脏器、血管切除的腹膜后肿瘤根治性切除个性化治疗方案。
(腹膜后及腹腔巨大肿物)
巨大的肿瘤导致手术难度增加,手术风险加大:第一,肿瘤巨大、累及范围广,腹腔可操作空间小,需要小心分离肿瘤周围粘连后,逐渐解剖游离肿瘤,增加手术视野;第二,肿瘤累及腹腔多个重要脏器,主要是左侧肾脏、左肾上腺、脾脏和胰腺,需要谨慎地将肿瘤与周围脏器游离分开,尽量保留各个重要脏器。第三,肿瘤侵犯多支腹腔重要血管,包括但不限于肠系膜上动脉、腹腔干动脉及左侧肾动脉等,需要在切除部分肿瘤后,减轻腹腔肿瘤负荷,增加手术视野,结合术前影像检查及术中所见,在可能出现重要腹腔动脉的位置小心解剖,直到充分暴露后予以血管牵引带悬吊,沿血管走形继续解剖,尽可能保护各腹腔重要分支动脉不被离断。
7月24日,手术进行。随着腹腔被缓缓打开,一个庞大肿瘤赫然出现在眼前。术中发现,这颗巨大肿瘤推挤了腹主动脉、左肾静脉、左肾动脉、胰腺、脾脏、左半结肠以及左侧输尿管。泌尿外科为患者安置了双侧输尿管支架,为术中减少输尿管损伤提供指引;胰腺外科、肝脏外科和胃肠外科为保护肝、胰腺功能以及肠道肿瘤切除方面提供了指导;输血科和麻醉科在术中维持患者生命循环稳定提供了支持。最终,在各个科室的全力配合下,赵纪春教授团队不仅完整切除了肿瘤,还成功保护了周围的重要脏器和大血管,避免了术中大出血等致命风险。手术耗时5个小时,多学科团队凭借丰富的经验和成熟的专业技能解除了这颗“定时炸弹”。


(术中)
术后,患者小吴转入外科重症监护室。1周后,小吴顺利停机拔管,转回血管外科病房。术后20天,小吴顺利康复出院。

(术前和术后对比图)

(切除的巨大腹膜后肿物)
腹膜后间隙前界为腹腔,后界为腹后壁,上界为第2肋及对应椎体,下界为骶骨表面及髂嵴所围成的区域,外侧界为腰方肌外侧缘,发生在此间隙的肿瘤为腹膜后肿瘤(腹膜后器官源性肿瘤除外)。腹膜后肿瘤发病率较低,仅占全身肿瘤发病率的0.1-0.2%。发生于腹膜后的软组织肿瘤以脂肪肉瘤最为常见,其次为平滑肌肉瘤,其他一些较为常见的肿瘤类型包括多形性未分化肉瘤(恶性纤维组织细胞瘤)、副神经节瘤(嗜铬细胞瘤)和恶性间皮瘤等。
腹膜后肿瘤发病率低,却涵盖了数十种组织学类型和生物学行为各异的肿瘤,加之解剖结构特殊、瘤体巨大,对放化疗不敏感,给相关治疗决策的制定及实施提出了更高的学术和技术要求。腹膜后分布着众多重要的脏器、血管和神经,肿瘤被发现时常常已包绕甚至侵犯重要脏器和大血管。手术风险大,术中极易出现大出血,因此腹膜后也被称为“手术禁区”。
我院血管外科平均每年收治130余例累及腹部大血管或复发的复杂疑难腹膜后肿瘤患者,患者来自全国各地。在赵纪春教授的带领下,血管外科团队对累及血管的腹膜后肿瘤予以根治性切除并同时进行血管重建或置换,显著提高了此类患者的预后,在腹膜后肿瘤的外科治疗领域达到国际先进水平。此次手术的成功,再次彰显了血管外科处理复杂疑难腹膜后肿瘤的高超水平以及我院多学科合作的团队默契。
300多万优质简历
17年行业积淀
2万多家合作名企业

微信扫一扫 使用小程序

